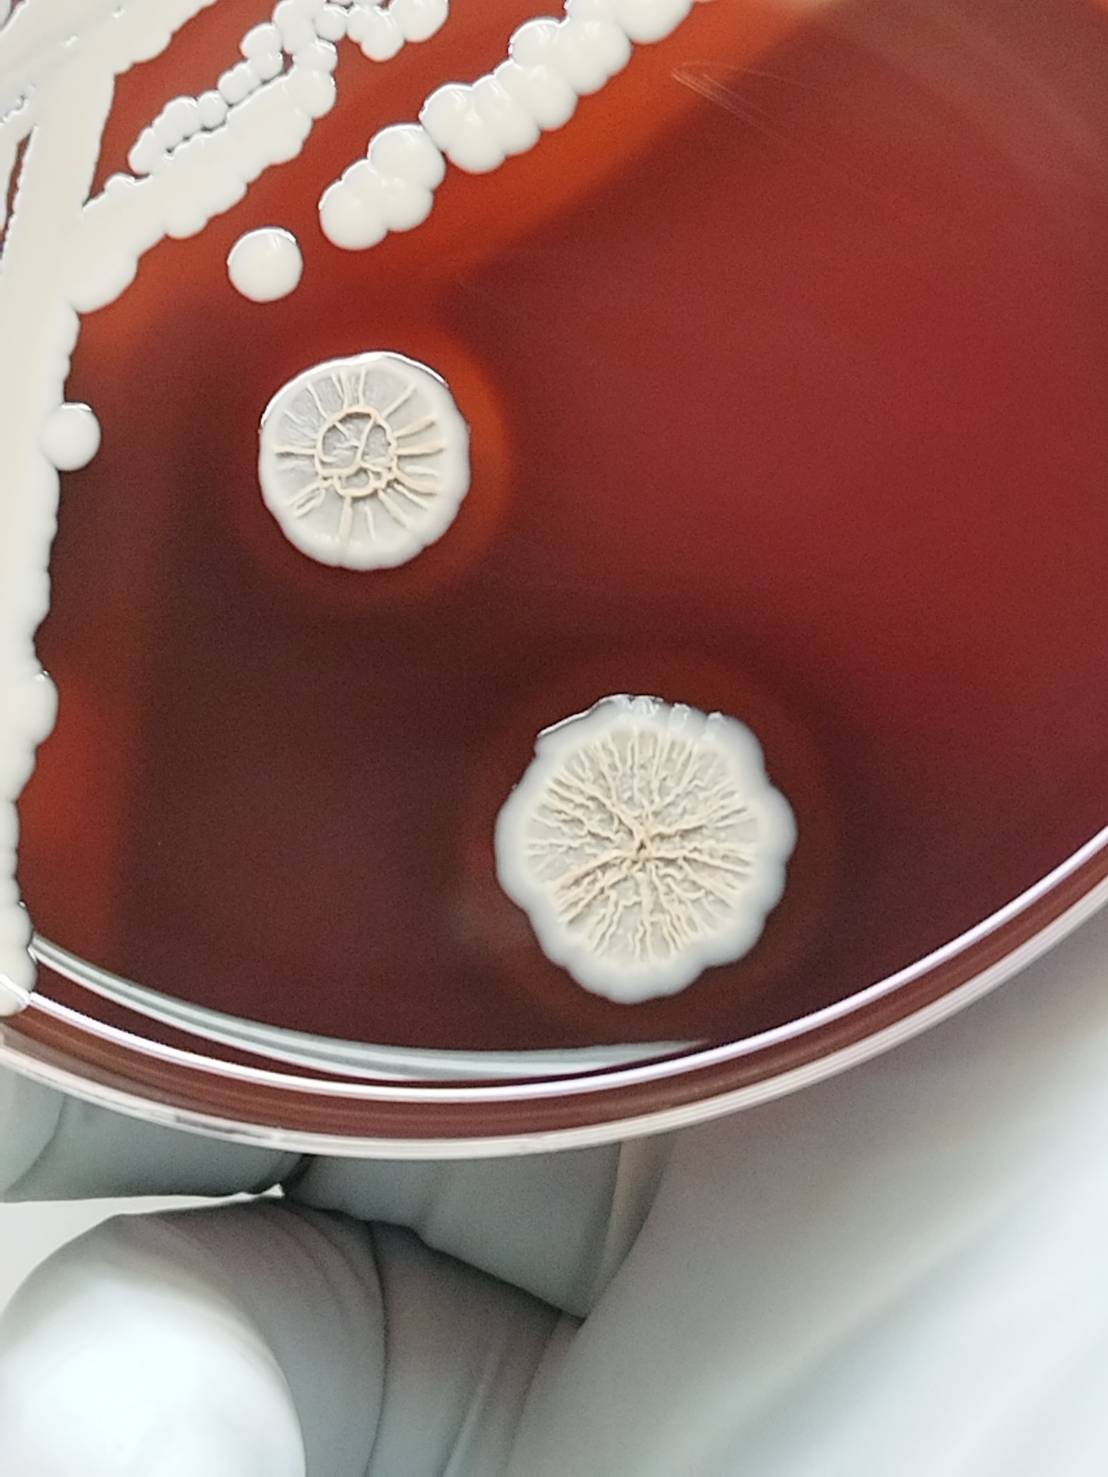

.jpg)
กรมวิทยาศาสตร์การแพทย์ กระทรวงสาธารณสุข เปิดเผยสถานการณ์โรคเมลิออยโดสิส หรือโรคไข้ดิน จากข้อมูลทางห้องปฏิบัติการพบแนวโน้มผู้ติดเชื้อเพิ่มขึ้น พร้อมให้บริการตรวจวินิจฉัยด้วยวิธีทางชีวโมเลกุล เพื่อสนับสนุนการวินิจฉัยและรักษาผู้ป่วยได้อย่างทันท่วงที และการเฝ้าระวังสายพันธุ์ดื้อยาต้านจุลชีพ
ดร.นพ.สราวุฒิ บุญสุข อธิบดีกรมวิทยาศาสตร์การแพทย์ กล่าวว่า จากกรณีพบผู้เสียชีวิตจากโรคเมลิออยโดสิส กรมวิทยาศาสตร์การแพทย์ในฐานะห้องปฏิบัติการอ้างอิงของประเทศ มีความพร้อมในการตรวจเชื้อก่อโรค โดยให้บริการตรวจวินิจฉัยแบบครบวงจร ประกอบด้วย การตรวจรวดเร็วทางซีรัมวิทยาเพื่อตรวจหาระดับแอนติบอดีในเลือด การเพาะเลี้ยงเชื้อ การตรวจสารพันธุกรรมด้วยวิธี real-time PCR การตรวจจีโนมเชื้อก่อโรค และการทดสอบความไวต่อยาต้านจุลชีพ โดยแพทย์จะใช้ผลตรวจร่วมกับอาการและประวัติของผู้ป่วยในการวินิจฉัยโรคและการรักษาผู้ป่วย
อธิบดีกรมวิทยาศาสตร์การแพทย์ กล่าวเพิ่มเติมว่า ในปีงบประมาณ 2568 สถาบันวิจัยวิทยาศาสตร์สาธารณสุข ได้รับตัวอย่างผู้ป่วยสงสัยโรคเมลิออยโดสิส จำนวน 177 ตัวอย่าง พบการติดเชื้อ 38 ตัวอย่าง คิดเป็นร้อยละ 21.5 โดยเป็นเพศชาย 110 ตัวอย่าง พบติดเชื้อ 23 ตัวอย่าง (ร้อยละ 20.9) และเพศหญิง 67 ตัวอย่าง พบติดเชื้อ 15 ตัวอย่าง (ร้อยละ 23.4) เมื่อเปรียบเทียบข้อมูลย้อนหลัง 4 ปี (พ.ศ. 2564–2567) พบว่ามีจำนวนตัวอย่างส่งตรวจรวม 542 ตัวอย่าง และพบการติดเชื้อ 40 ตัวอย่าง คิดเป็นร้อยละ 7.4 สะท้อนให้เห็นว่าอุบัติการณ์ของโรคเมลิออยโดสิสมีแนวโน้มเพิ่มสูงขึ้นอย่างชัดเจน
นอกจากนี้ กรมวิทยาศาสตร์การแพทย์ยังมีศักยภาพในการตรวจวินิจฉัยด้วยวิธี real-time PCR จากสิ่งส่งตรวจโดยตรง เช่น เลือด serum plasma และขวด hemoculture ซึ่งช่วยเพิ่มความรวดเร็วและความแม่นยำในการยืนยันผลทางห้องปฏิบัติการ อีกทั้งมีการตรวจวิเคราะห์โดยไม่คิดค่าใช้จ่ายในกรณีตรวจยืนยันเชื้อก่อโรคด้วยการวิเคราะห์จีโนม โดยเฉพาะในเชื้อที่อาจจำแนกผิดพลาดหรือสายพันธุ์ใกล้เคียงอื่นๆ และมีการเฝ้าระวังสายพันธุ์ดื้อยา ด้วยการทดสอบความไวต่อยาต้านจุลชีพและการศึกษายีนดื้อยา
ดร.นพ.สราวุฒิ กล่าวย้ำว่า โรคเมลิออยโดสิส เป็นโรคติดเชื้อแบคทีเรีย Burkholderia pseudomallei ที่พบในดินและน้ำ โดยมักพบการระบาดในช่วงฤดูฝน และสามารถพบได้ในทุกภูมิภาคของประเทศไทย เชื้อสามารถเข้าสู่ร่างกายผ่านบาดแผล การสูดดมฝุ่นดิน หรือการดื่มน้ำที่ปนเปื้อน อาการมีตั้งแต่ไข้สูง หายใจลำบาก แน่นหน้าอก ไปจนถึงมีแผลบวมแดงหรือฝีหนอง และหากเชื้อเข้าสู่กระแสเลือด อาจทำให้เกิดภาวะติดเชื้อรุนแรงและเสียชีวิตได้ อย่างไรก็ตาม โรคนี้สามารถรักษาให้หายได้ หากได้รับการวินิจฉัยและรักษาอย่างรวดเร็ว ดังนั้น ประชาชนที่มีความเสี่ยง หากมีอาการผิดปกติ เช่น มีไข้สูงต่อเนื่อง หรือมีประวัติสัมผัสดินและน้ำ ควรรีบพบแพทย์โดยเร็ว เพื่อป้องกันภาวะแทรกซ้อนที่รุนแรง และตรวจยืนยันสำหรับการรักษาระยะต่อเนื่องเพื่อป้องกันการกลับเป็นซ้ำ
สำหรับสถานพยาบาลที่ต้องการส่งตรวจวินิจฉัยโรคเมลิออยโดสิสทางห้องปฏิบัติการ หรือสอบถามข้อมูลเพิ่มเติม สามารถติดต่อได้ที่ ศูนย์เฝ้าระวังและประสานงานทางห้องปฏิบัติการ สถาบันวิจัยวิทยาศาสตร์สาธารณสุข กรมวิทยาศาสตร์การแพทย์ โทร. 0-2951-0000 ต่อ 98340 และ 99614 หรือประสานงานส่งต่อตัวอย่างได้ที่ศูนย์วิทยาศาสตร์การแพทย์ในพื้นที่
*******22 เมษายน 2569*******
ข่าวประชาสัมพันธ์เกี่ยวข้อง
แผนผังเว็บไซต์
- นโยบายธรรมภิบาล
- ภารกิจ และหน้าที่รับผิดชอบของหน่วยงาน
- วิสัยทัศน์ & พันธกิจ & ยุทธศาสตร์
- ประวัติความเป็นมา
- นโยบายคุณภาพ
- แผนกลยุทธ์กรมวิทยาศาสตร์การแพทย์
- แผนการปฏิบัติราชการและ แผนการใช้จ่ายงบประมาณ
- โครงสร้างหน่วยงาน
- ทำเนียบผู้บริหาร
- ทำเนียบผู้ทรงคุณวุฒิ
- ซีไอโอ
- เว็บไซต์ส่วนกลาง
-
- สถาบันวิจัยวิทยาศาสตร์สาธารณสุข
- สถาบันชีววิทยาศาสตร์ทางการแพทย์
- สำนักงานคณะกรรมการพิจารณาการศึกษาวิจัยในคน
- สำนักงานเลขานุการกรม
- กลุ่มงานจริยธรรม
- กลุ่มตรวจสอบภายใน
- กลุ่มพัฒนาระบบบริหาร
- กองความร่วมมือระหว่างประเทศ
- กองประชาสัมพันธ์และสื่อสารสาธารณะ
- กองทดสอบความชำนาญ
- กองแผนงานและวิชาการ
- กองบริหารทรัพยากรบุคคล
- ศูนย์รวมบริการ
- ศูนย์เทคโนโลยีสารสนเทศและการสื่อสาร
- สถาบันชีววัตถุ
- สถาบันวิจัยสมุนไพร
- สำนักเครื่องสำอางและวัตถุอันตราย
- สำนักคุณภาพและความปลอดภัยอาหาร
- สำนักมาตรฐานห้องปฏิบัติการ
- สำนักยาและวัตถุเสพติด
- สำนักรังสีและเครื่องมือแพทย์
- สำนักผู้ทรงคุณวุฒิกรมวิทยาศาสตร์การแพทย์
- เว็บไซต์ส่วนภูมิภาค
-
- ศูนย์วิทยาศาสตร์การแพทย์ที่ 1 เชียงใหม่
- ศูนย์วิทยาศาสตร์การแพทย์ที่ 1/1 เชียงราย
- ศูนย์วิทยาศาสตร์การแพทย์ที่ 2 พิษณุโลก
- ศูนย์วิทยาศาสตร์การแพทย์ที่ 3 นครสวรรค์
- ศูนย์วิทยาศาสตร์การแพทย์ที่ 4 สระบุรี
- ศูนย์วิทยาศาสตร์การแพทย์ที่ 5 สมุทรสงคราม
- ศูนย์วิทยาศาสตร์การแพทย์ที่ 6 ชลบุรี
- ศูนย์วิทยาศาสตร์การแพทย์ที่ 7 ขอนแก่น
- ศูนย์วิทยาศาสตร์การแพทย์ที่ 8 อุดรธานี
- ศูนย์วิทยาศาสตร์การแพทย์ที่ 9 นครราชสีมา
- ศูนย์วิทยาศาสตร์การแพทย์ที่ 10 อุบลราชธานี
- ศูนย์วิทยาศาสตร์การแพทย์ที่ 11 สุราษฎร์ธานี
- ศูนย์วิทยาศาสตร์การแพทย์ที่ 11/1 ภูเก็ต
- ศูนย์วิทยาศาสตร์การแพทย์ที่ 12 สงขลา
- ศูนย์วิทยาศาสตร์การแพทย์ที่ 12/1 ตรัง
- กฏหมาย ระเบียบ และข้อบังคับที่เกี่ยวข้อง
- รายงานประจำปี











